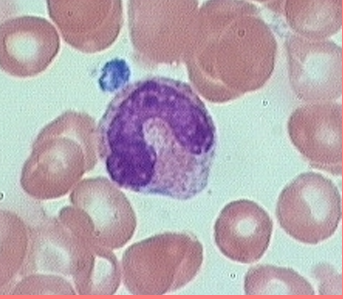
<p><span style="font-family: Arial, sans-serif;">agranular (lack visible cytoplasmic granules)</span></p><p class="MsoNormal"><strong>3-8%</strong> of the WBCs</p><p class="MsoNormal">Nucleus kidney or horse-shoe shaped</p><p class="MsoNormal"> • Largest WBC</p><p class="MsoNormal">Migrate to infected tissues– Differentiate into macrophage</p><ul><li><p class="MsoNormal">differentiate into phagocytes</p></li></ul><p class="MsoNormal">o<span style="font-family: "Times New Roman"; line-height: normal; font-size: 7pt;"> </span>V<strong><u>iruses/fungal</u></strong></p><p class="MsoNormal">o<span style="font-family: "Times New Roman"; line-height: normal; font-size: 7pt;"> </span>I<strong><u>ntracellular bacterial parasites</u></strong></p><p><span style="font-family: Arial, sans-serif;"><strong><u>Chronic infections (tuberculosis)</u></strong></span></p><p>Fixed in some tissues</p><p>– Lungs, lymph nodes</p><p> • Destroy microbes and clean up dead tissue</p><p>Low count indicates Bone Marrow Suppression, Treatment with Cortisol</p>

1/122
Looks like no tags are added yet.
Name | Mastery | Learn | Test | Matching | Spaced | Call with Kai |
|---|
No analytics yet
Send a link to your students to track their progress
Blood
Plasma
– Water– Proteins– Solutes
• Formed Elements– Red Cells – White cells– Platelets
fluid connective tissue
functions: transportation, regulation, and protection

Hematocrit
percentage of erythrocytes in whole blood
– Adult females
• 38-46%
– Adult males
• 40-54%
The difference is primarily due to hormones, especially testosterone, which stimulates red blood cell production, while estrogen tends to suppress it. Men also have greater muscle mass and oxygen demand, and women experience menstrual blood loss

Blood volume
5 to 6 liters (1.3- 1.56 gallons) in average male
– 4 to 5 liters in average female
Erythrocytes
Functions
• Carries– Oxygen– Carbon dioxide– Nitric oxide
• Local vasodilator
Formed elements of blood
the cellular components of blood, they’re called this because they are actual cells or cell fragments, as opposed to plasma, which is the fluid portion.
-Red blood cells (erythrocytes)
• White blood cells (leukocytes)
– Granular Leukocytes (nucleus looks segmented) • Neutrophils • Eosinophils • Basophils
– Agranular (nucleus is whole) Leukocytes • Lymphocytes • Monocytes • Platelets
45% of whole blood

Basophil
dark blue/purple granules
• S-shaped, bilobed nuclei
• 8 to 10 microns
<1%
High in allergic reaction or hypothyroidism
• Leave capillaries
– Enter connective tissue as mast cells
• Release heparin, histamine & serotonin
– Heighten inflammatory response
• Low count indicates Pregnancy, Ovulation, Stress, or Hyperthyroidism

Neutrophil
pale pink, lilac, or light purple granules
Fights bacteria
• Present
– Infections-first on site
– Burns
-Stress

Small lymphocyte
Agranular
• Round nucleus
• Small cells 6 - 9 microns
• Large cells 10 - 14 microns
– increase in number during viral infections
• 20 to 25% of circulating WBCs
Functions:
B cells
– destroy bacteria and their toxins
– turn into plasma cells that produces antibodies
• T cells
– attack viruses, fungi, transplanted organs, cancer cells & some bacteria
• Natural killer cells
– attack many different microbes & some tumor cells
– destroy foreign invaders by direct attack

Monocyte
Agranular
• Nucleus kidney or horse-shoe shaped
• Largest WBC
• Diameter is 12 - 20 microns
• 3 to 8% of circulating WBC
Functions:
Viral or fungal infections
• Migrate to infected tissues
– Differentiate into macrophages
• Fixed in some tissues– Lungs, lymph nodes
• Destroy microbes and clean up dead tissue

Anemia
insufficient oxygen carrying capacity of blood
-formation, destruction, loss
low RBCs or hemoglobin
Symptoms– fatigue, cold intolerance & paleness
Normal counts
In order of abundance:
• Neutrophils 60-70%
-High in bacterial infection
• Lymphocyte 20-25%
-High in viral infection
• Monocytes 3 -- 8 %
-High in fungal/viral infection
• Eosinophil 2 -- 4 %
-High in parasitic or allergic reactions
• Basophil <1% High in allergic reaction or hypothyroidism
Nicely (Never) Let Monkeys Eat Bananas
Polycythemia
too many red blood cells (over 65%)
means your blood is too thick, increasing risks of blood clots, heart attack, or stroke. Causes include dehydration, tissue apoxia, blood doping in athletes
Leukocytosis
too many leukocytes
usually means your immune system is responding to infection, inflammation, stress, or medications

thrombocytosis
a condition where the body produces excess platelets, causing the blood to become too sticky. It often causes no symptoms but can lead to dangerous, life-threatening blood clots, strokes, or bleeding
Neutrophilia
too many neutrophils
a sign that your body is fighting infection, inflammation, stress, or injury. Common causes include bacterial infections, injury, smoking, and medication side effects
Lymphocytosis
too many lymphocytes
often indicating an immune response to viral infections, or chronic inflammatory conditions
Monocytosis
high monocytes
indicates your immune system is active, often due to chronic infections, inflammation, autoimmune diseases, or cancer
high in fungal/viral infection

eosinophilia
high eosinophils
often signaling allergies, infections (parasitic/fungal), autoimmune diseases, or blood disorders.
basophilia
high basophils
often indicate that your immune system is responding to an allergen, infection, or chronic inflammation.

Pernicious anemia
an autoimmune condition where the body cannot properly absorb vitamin B12 due to a lack of "intrinsic factor" in the stomach, leading to decreased, malfunctioning red blood cells
Buffy coat
a thin, pale-colored (whitish-tan) layer containing concentrated white blood cells and platelets that forms between the plasma and red blood cells when anticoagulated blood is centrifuged.
< 1% of whole blood. Leukocytes and platelets

Plasma
55% of whole blood
Plasma 90% water
o 8% plasma proteins
2% other substances - organic nutrients, electrolytes, gases, hormones etc

Plasma Proteins
produced by the liver
· Albumin
o 60% of plasma proteins – oncotic pressure
· Fibrinogen
o 4% of plasma proteins - blood clotting or coagulation
· Globulin
o 36% of plasma proteins -
o alpha - transport proteins; and beta - antibodies

Erythrocytes (red blood cells)
contains hemoglobin – transports gases
· life span 100-120 days
· 45% of blood
Leukocytes (white blood cells)
Granulocytes and agranulocytes
Lymphocytes
agranular (lack visible cytoplasmic granules)
Round nucleus
• Small cells 6 - 9 microns
• Large cells 10 - 14 microns
– increase in number during viral infections
About 25% of the WBCs
T lymphocytes (T cells) - immune response
B lymphocytes (B cells) - produce antibodies

Monocytes
agranular (lack visible cytoplasmic granules)
3-8% of the WBCs
Nucleus kidney or horse-shoe shaped
• Largest WBC
Migrate to infected tissues– Differentiate into macrophage
differentiate into phagocytes
o Viruses/fungal
o Intracellular bacterial parasites
Chronic infections (tuberculosis)
Fixed in some tissues
– Lungs, lymph nodes
• Destroy microbes and clean up dead tissue
Low count indicates Bone Marrow Suppression, Treatment with Cortisol
Neutrophils
granular (Neutral-staining cytoplasmic granules)
50-70% of the WBCs
phagocytize bacteria
High in bacterial infection
• Low indicates Radiation Exposure, Drug Toxicity, B12 Deficiency, Systemic Lupus Erythematosus
Nuclei 2 to 5 lobes
• Older cells more lobes
• Young cells – Horseshoe shaped nucleus (band)
• Fine, pale lilac granules
• 10-12 microns
Present
– Infections-first on site
– Burns
– Stress

Eosinophils
granular (acidic-staining cytoplasmic granules)
2-4% of the WBCs. High in allergies
Nucleus 2 or 3 lobes connected by thin strand
· Kill parasitic worms
· Phagocytize/destory antigen-antibody complexes
· Inactivate certain inflammatory chemicals
Release histaminase
–Slows down inflammation caused by basophils
• Large, orange-red granules
• 10 to 12 microns
Low count indicates Drug toxicity, Stress

Basophils
granular (Basic-staining cytoplasmic granules)
0.5-1% of the WBCs
Release histamine, heparin, and serotonin
Raised in inflammations

Platelets
blood clotting
Thrombocytopenia
low platelet count
often causing easy bruising, tiny red/purple skin spots (petechiae), nosebleeds, and bleeding gums. It is caused by reduced bone marrow production, increased destruction, or splenic trapping.
Plasma vs serum
Plasma is the liquid part of blood with clotting factors still present (including fibrinogen).
Serum is the liquid part of blood after clotting has occurred, so clotting factors are removed/used up.

Polycythemia
Excess RBCs (over 65%)
– Dehydration, tissue hypoxia, blood doping in athlete
Iron-deficiency anemia/microcytic anemia
Inadequate absorption or loss of iron

Hemorrhagic anemia
Loss of RBCs due to bleeding
Hemolytic anemia
Inherited, defects in cell membranes cause rupture
-include sickle cell and thalassemia

Thalassemia anemia
Hereditary deficiency of hemoglobin

aplastic anemia
Destruction of bone marrow (radiation/toxins)

sickle-cell anemia
Genetic defect
– Abnormal hemoglobin
– Very low O2
• RBC deformed by changes in hemoglobin
– Sickle-shaped cells rupture easily

Megaloblastic anemia
folate deficiency

Blood crossmatching
test to determine/judge the compatibility between donor cells and recipient serum
Drop antisera A, B, D and recipient’s serum on clean palettes
• Drop the sample to be tested (donor blood) into each well
• Stir with different stirrers
• Observe after 60 seconds for agglutination

Agglutination
antigen-antibody rxns
blood clumps together w/ hazardous outcomes
Other antigens/factors that can affect blood incompatibility
Kelly factor
Coombs factor
Duffy factor
What are the 4 cavities the heart is located in?
-Pericardial
-Mediastinal
-Thoracic
-Ventral
Where is the apex of the heart located?
5th left intercostal space in the mid-clavicular line

Cardiac muscle
shape of fibers
short, cylindrical, and branched cells (often X or Y-shaped) that connect end-to-end via specialized junctions called intercalated discs.
nuclei
Each cell typically contains one or two centrally located, oval-shaped nuclei

Skeletal muscle
lack intercalated discs
relies on innervation for contraction and stores glycogen (approx. 1% of mass) as a primary fuel source for energy-intensive, fast-twitch, or slow-twitch muscle activity

Blood flow direction in the heart
moving from the body to the right side (deoxygenated), to the lungs, then to the left side (oxygenated), and finally out to the body. The cycle follows this path: superior or inferior vena cava —> right atrium —> tricuspid valve —>right ventricle —> pulmonary semilunar valve —→ pulmonary artery —> lungs —> pulmonary veins —> left atrium —> bicuspid (mitral valve) —→ Left ventricle —> aortic semilunar valve —> aorta

EKG-electrocardiogram
Graphic representation of the electrical events
•P wave – atrial depolarization (blood intro ventricles)
•QRS complex – Ventricular depolarization (push blood out of body to lungs)
•T wave – ventricular repolarization (ventricles fill with blood, relaxing “reset” phase)
What of atrial repolarization? —> none, no wave on the EKG that represents this

Electrical events of the heart
SA (sinoatrial) node—> pacemaker of the heart

3 categories of arteries

BLOOD TYPING
Erythrocyte surface has ANTIGENS
• Two major types
– AB
– R

ABO GROUPING
Type A
– People with A Antigens
• Type B
– People with B Antigens
• Type AB
– People with A + B Antigens
• Type O
– People with neither Antigen

Antibodies
Make incompatible blood cells agglutinate
• They clump and rupture
People manufacture antibodies against the antigens that they don’t have.
• Type A makes
– Anti B
• Type B makes
– Anti A
• Type O makes
– Anti A and Anti B
• Type AB makes
–Neither
Transfusions
1. Donor’s antibodies don’t matter much.
They get diluted in the recipient’s bloodstream,
so they rarely cause a reaction.
2. Recipient’s antibodies do matter.
If the recipient’s antibodies recognize the donor’s antigens,
they will agglutinate (clump) the donor’s red blood cells.
Rh (rhesus factor)
Rh+ individuals
– Have Rh antigens on their red cells (No anti-D antibodies unless exposed)
– Most common
• Rh- individuals
– Have no Rh antigens (may produce anti-D if exposed to Rh+ blood)
– Have no Rh antibodies at first
If an Rh- individual receives Rh+ blood
– The first time no problem but
• Rh- person makes Rh antibodies
– The second time Rh antibodies will clump with Rh+ blood
Can be present (+ or D) or absent (- or d)
o Rh+ can receive from both + and –
o Rh– can ONLY receive ONLY from –

The heart
Location
The sits in the ventral body cavity
→ specifically inside the thoracic cavity
→ inside the mediastinum (the central compartment of the thorax)
🔀 Double Pump System
The heart works as two pumps in one organ:
Right side of the heart
Sends blood to the lungs
This is the pulmonary circuit
Left side of the heart
Sends blood to the body
This is the systemic circuit
📍 Base of the heart
The superior (top) portion
Broad, flat region where the great vessels attach
formed by the left atrium (about two-thirds) and a smaller portion of the right atrium
Apex of the heart
The inferior (bottom) pointed tip
Formed by the left ventricle
Points down, forward, and to the left

Pericardium
Sac surrounds heart
• Layers
– Fibrous pericardium- thick
– Serous pericardium- thin
• Outer parietal layer
– Fused to fibrous pericardium
• Inner visceral layer (Epicardium)
– Attached to heart muscle
– Pericardial space between parietal and visceral layers
• Pericardial fluid inside
•Pericarditis

Epicardium
Visceral serous pericardium
Endocardium
Thin lining

Heart chambers
Four chambers
– 2 atria
– 2 ventricles

Atria
Receiving chambers
– Receive blood from
• Body
• Lungs
Right atrium
– Receives blood from the body
Right Atrial Structures
Interatrial septum (wall)
• partitions the atria
• Fossa ovalis
– remnant of the fetal foramen ovale

Left atrium
– Receives oxygenated blood from lungs
– Forms most of the base of the heart
Auricles
right and left
small, ear-shaped, muscular pouches projecting from the right and left atria of the heart

Ventricles
Main pumping chambers
– Receive blood from the atria
– Send it to the body and lungs
• Right Ventricle (Space)
– Sends blood to lungs
Left ventricle
– Sends blood to the body
– Forms the apex of heart
• Interventricular septum
– Wall between the ventricles

Major Vessels of the Heart
Arteries
– Carry blood away from the heart
• Veins
– Carry blood to the heart
• Do arteries carry oxygenated or deoxygenated blood?

Vena Cavas
Superior Vena cava
– Deoxygenated blood from upper body
• To Right ventricle
• Inferior Vena cava
– Deoxygenated blood from lower body
• To Right ventricle
• Opening of Cardiac Sinus
– Deoxygenated blood from the heart

Pulmonary Veins
carry
– Oxygenated blood from the lungs
– To the left atria
– Note –These veins carry oxygenated blood

Aorta
– Ascending aorta
– Arch of aorta
– Descending aorta
• Carries oxygenated blood from the left ventricle
– To the body

Valves
• Direct the flow of blood
– In one direction
– Between chambers and vessels
• Chordae tendineae
– Tendon-like cords
• Connect valve cusps and papillary muscles
• Papillary muscles
– Hold valve flaps
– Prevent flaps from flipping up or everting

AV Valves (atrioventricular)
Tricuspid valve
– Directs flow from right atria to right ventricle
• Bicuspid
– Directs flow from left atria to left ventricle

Pulmonary Semilunar Valve
Directs from from the right ventricle to the Pulmonary trunk

Aortic semilunar valve
Directs flow from the left ventricle to the Aorta

Trabeculae carnae

Structure of a blood vessel
The 3 tunics
oEpithelium
oMuscle
oConnective tissue

Antigen (agglutinogen)
Complex protein on surface of cells. Determines blood type
Antibody(agglutinin)
Immune proteins in serum. Fights against antigens

Antigen-antibody complexes
Agglutination (clumping) of blood due to incompatibility

Mediastinum
-this area is part of the thoracic cavity
- the heart is snugly enclosed within this area

Pericardium
-A doubled layered sac
Fibrous pericardium
· loosely fitting superficial part of the sac
· protects the heart
· anchors it to surrounding structures
· prevents overfilling
Serous pericardium
· A slippery thin two layered membrane
o parietal layer
lines the internal surface of the pericardium
o visceral layer or epicardium
covers the external surface of the heart

Pericardial cavity
is between the parietal and visceral layers
this area contains a film of serous fluid termed pericardial fluid

Atrioventricular/coronary sulcus

Interventricular sulcus

Myocardium
middle layer - cardiac muscle
Cardiac muscle tissue responsible for heart contraction; thickest in the left ventricle.

Endocardium
simple squamous epithelium. Lines chambers and valves

Interatrial septum
o Muscular partition between the two atria
Has the fossa ovalis (remnant of the fetal foramen ovale)

O-
universal RBC donor
can only receive from O-
O+
can donate to O+, A+, B+, AB+
can receive from O+ and O-
A-
can donate to A-, A+, AB-, AB+
can receive from A- and O-
A+
can donate to A+ and AB+
can receive from A+, A-, O+, O-
B-
can donate to B-, B+, AB-, AB+
can receive from B- and O-
B+
can donate to B+ and AB+
can receive from B+, B-, O+, and O-
AB-
can donate to AB- and AB+
can receive from AB-, A-, B-, and O-
AB+
can donate to AB+ only
can receive from everyone
Rhesus isoimmunization
a condition where an Rh-negative pregnant person’s immune system produces antibodies against Rh-positive fetal red blood cells. This mismatch, often triggered by a prior miscarriage, trauma, or pregnancy, can cause dangerous hemolytic disease of the fetus/newborn (HDN) in subsequent pregnancies. It is treated with Rho(D) immune globulin injections

Where is the heart located anatomically?
Between these four cavities: Pericardial, Mediastinal, Thoracic, and ventral

Layers of the Heart (from outermost → innermost)
1. Pericardium (the covering)
This is the protective sac around the heart.
a. Fibrous pericardium
Tough, outer layer
Anchors the heart in place
b. Serous pericardium
A thin, double‑layered membrane:
Parietal layer — lines the inside of the fibrous pericardium
Visceral layer (epicardium) — directly on the heart surface
Between these two is the pericardial cavity filled with serous fluid to reduce friction.
2. Myocardium
The thick, muscular layer
Responsible for contraction
This is the layer that actually pumps blood
3. Endocardium
Thin, smooth inner lining
Lines the chambers and covers the valves
Continuous with blood vessel endothelium
🌟 Ultra‑simple version
Epicardium = outer layer
Myocardium = muscle
Endocardium = inner lining
And the pericardium is the protective sac around all of it.
